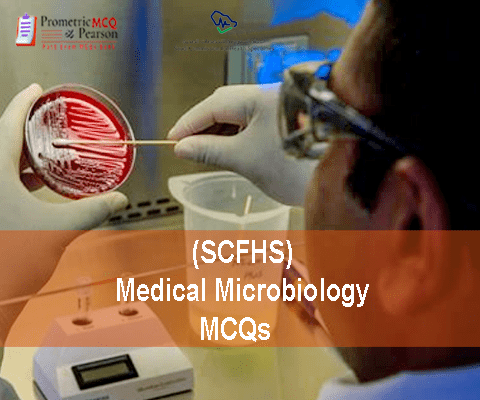

Description
Conquer the SCFHS Medical Microbiology Licensing Exam: Your Ultimate Study Solution
This comprehensive study package is your ultimate key to success on the Saudi Commission for Health Specialties (SCFHS) Medical Microbiology Licensing Exam. We provide 1500 meticulously crafted past exam MCQs and case studies, covering all essential topics to ensure you’re fully prepared for exam day. Whether you’re a registrar aiming for a 65% passing score or a senior registrar targeting 70%, our resource will help you achieve your goal.
Unmatched Licensing Exam Coverage:
Our study materials provide in-depth coverage of all essential exam topics, mirroring the official SCFHS weighting:
- Bacteriology (40%): Master the identification, classification, and pathogenesis of bacteria. Learn about bacterial genetics, antibiotic resistance, and laboratory diagnostic techniques.
- Virology (15%): Develop a strong understanding of viral structure, replication, and pathogenesis. Learn about viral diagnostic methods, antiviral therapies, and emerging viral diseases.
- Mycology (5%): Gain expertise in fungal identification, classification, and pathogenesis. Learn about antifungal therapies and laboratory diagnostic techniques.
- Parasitology (5%): Develop a thorough understanding of parasitic infections, including their life cycles, transmission, and diagnosis. Learn about antiparasitic therapies and disease management.
- Infectious Disease (15%): Gain a comprehensive understanding of infectious disease epidemiology, pathogenesis, diagnosis, and treatment. Learn about infection control measures and public health strategies.
- Molecular Microbiology (5%): Master the principles and techniques of molecular microbiology, including PCR, sequencing, and other advanced methods.
- Immunology/Serology (10%): Develop a strong understanding of immune responses, serological testing, and immunologic techniques. Learn to interpret laboratory results and correlate them with clinical findings.
- Infection Control (5%): Learn about infection prevention and control strategies, including sterilization, disinfection, and hand hygiene. Understand the importance of infection control in healthcare settings.
Key Features:
- 1500+ MCQs & Case Studies: Practice extensively with a vast array of questions mirroring the actual exam format, building your confidence and identifying knowledge gaps.
- Expert Guidelines: Benefit from expert insights and strategies to optimize your exam preparation and maximize your chances of success.
- Detailed Explanations: Understand the rationale behind each answer, reinforcing your learning and improving your comprehension.
- Structured Approach: Our organized format ensures you cover all topics systematically, making your study more efficient and effective.
- Up-to-Date Content: Stay current with the latest advancements and guidelines in medical microbiology.
Why Choose Our Study Package?
Our package isn’t just a collection of questions; it’s a complete learning experience designed to empower you with the knowledge and skills needed to excel in your career. We help you transform your preparation from rote memorization into genuine understanding, making you a more confident and competent medical microbiology professional.

Reviews
There are no reviews yet.